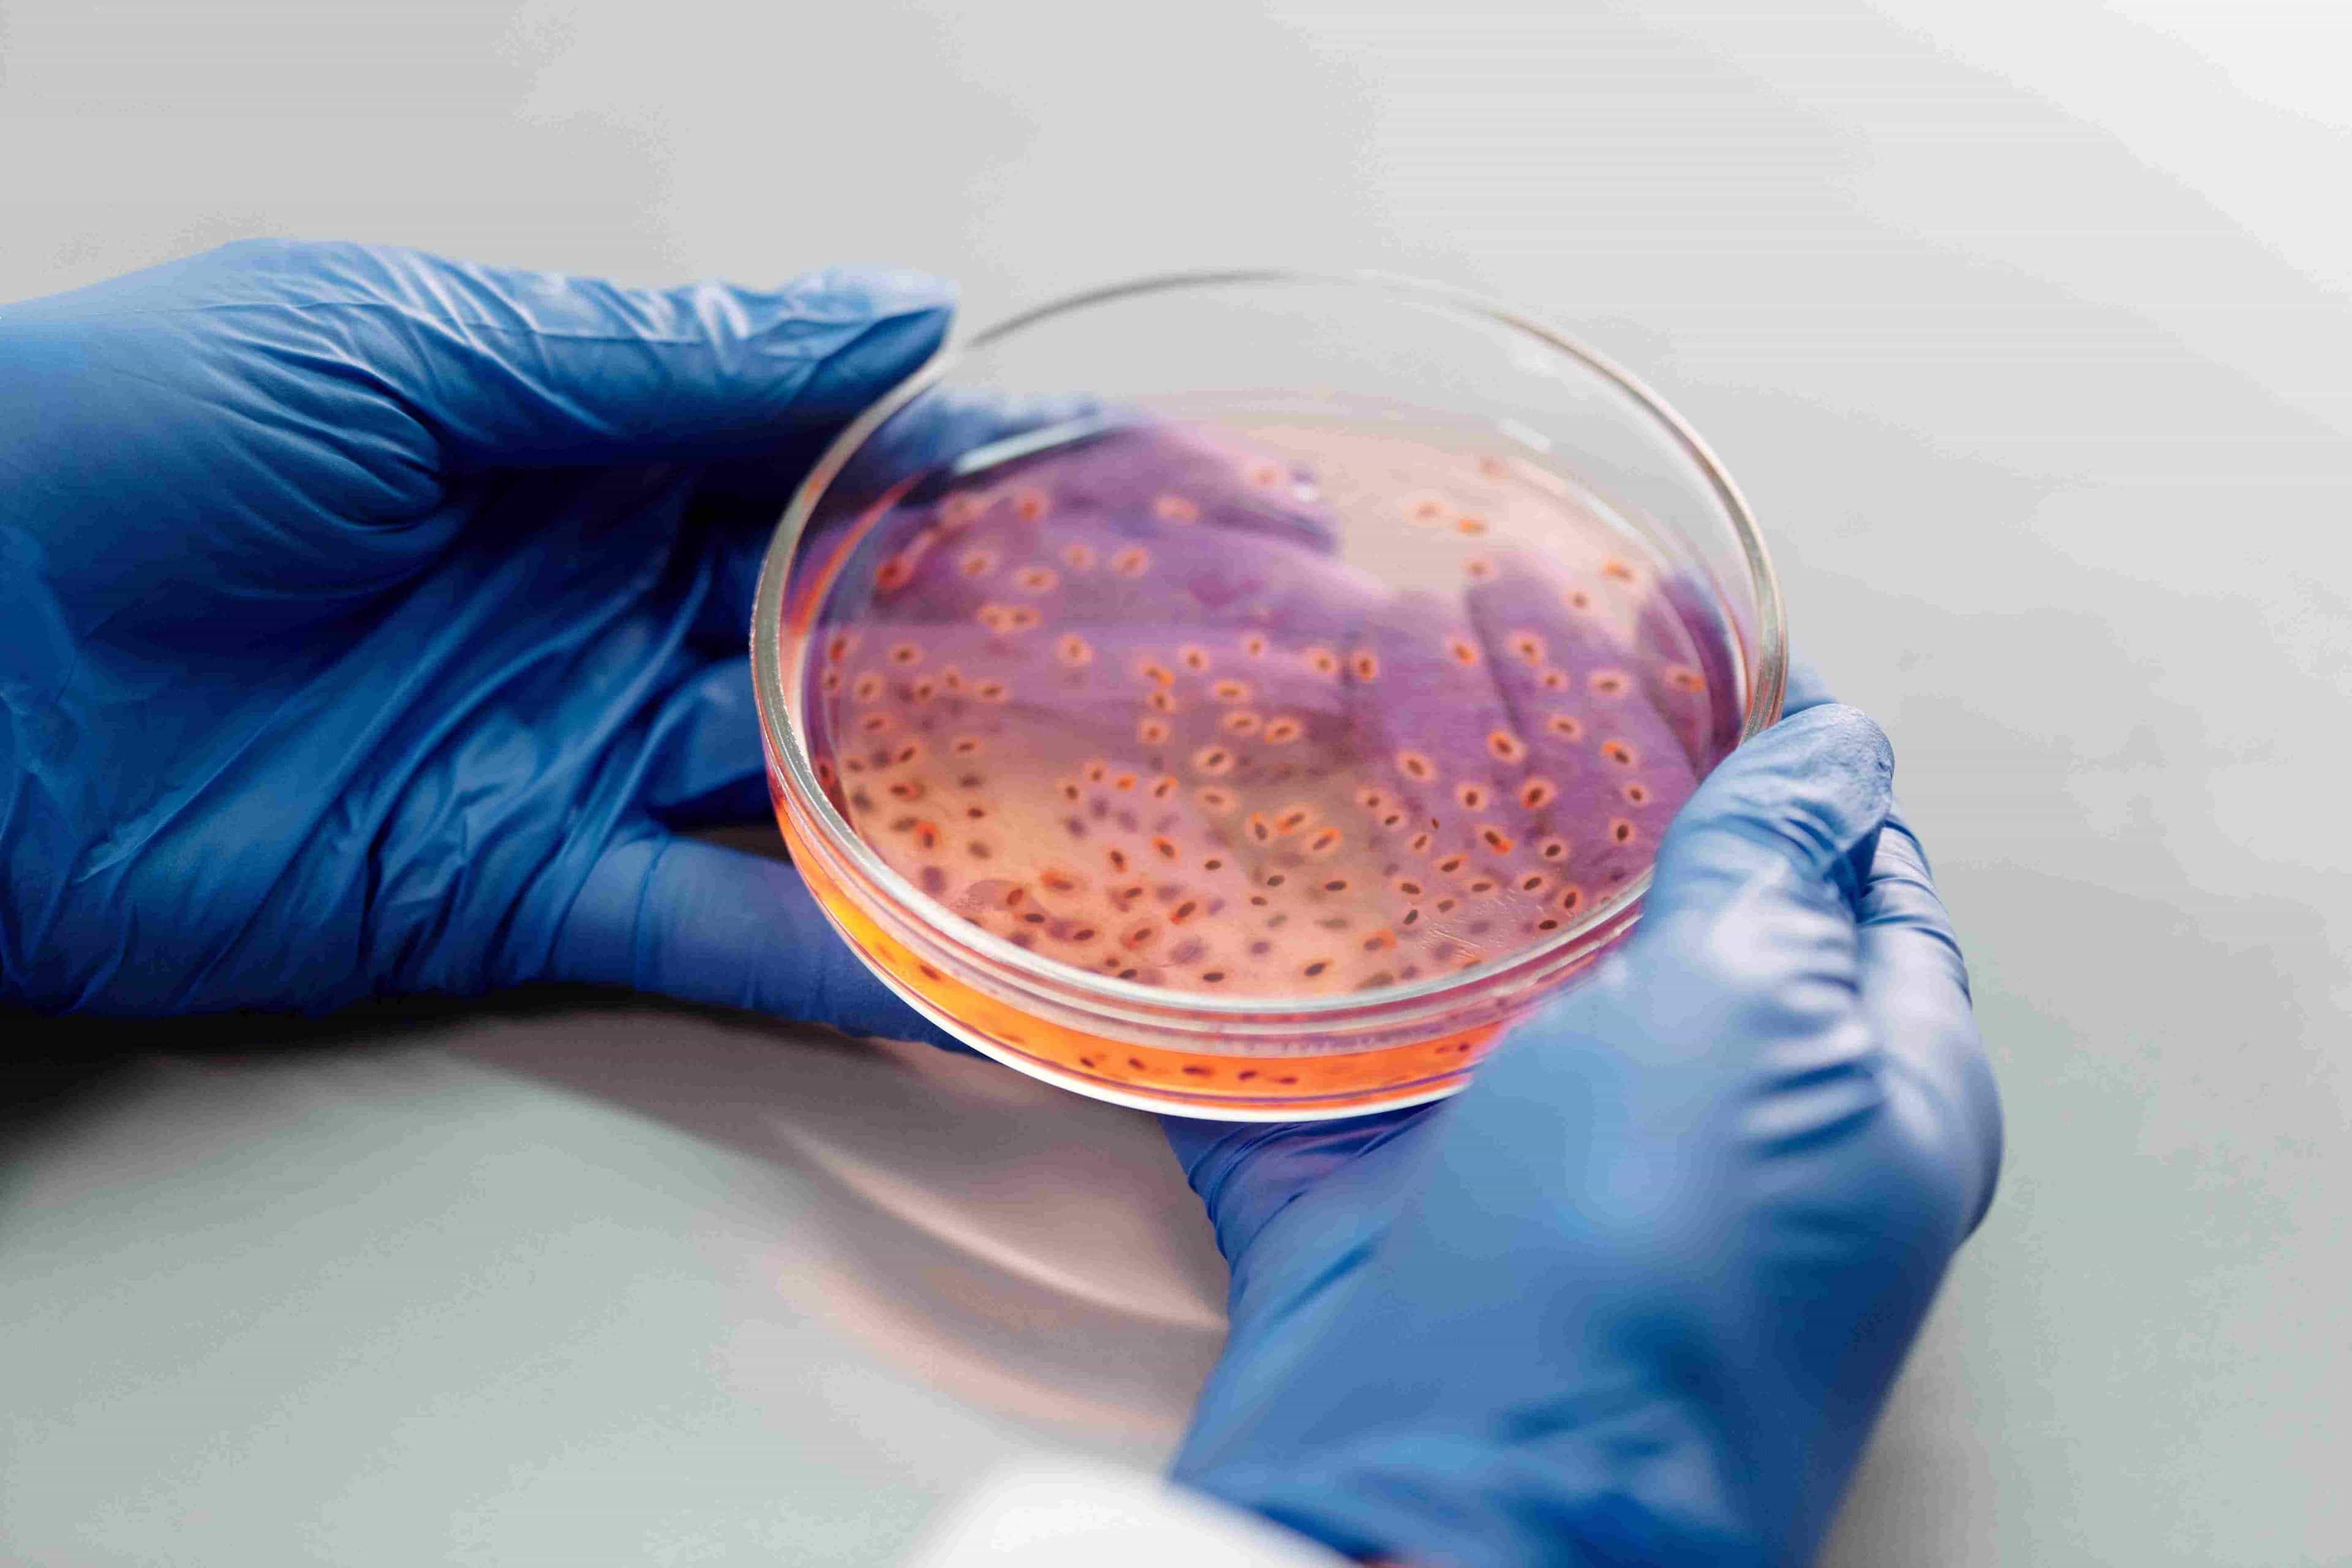
Metagenomic Analysis (Shotgun method)

Finoseq
High skilled faculty member
World's top provider of Genomics services.
Supports for both offline and online training
Solutions for High-Genome Research that are Affordable.

WHAT OUR STRENGTH?
Finoseq satisfies customer expectations
Skilled Faculty
Learn More
Premium Services
Learn More
Customer Services
Learn More
Daily Training
Learn More
ABOUT US
The service we offer is specifically designed to meet your needs.
Finoseq is a Bioinformatics service provider company with wide array of expertise in Genomics algorithm development, next generation sequencing (NGS) and CADD, Bioinformatics services. We serve to trusted life science partner from Universities and Institutes that makes reliable way to accelerate research. The network of expertise and commitment towards our best services to our clients will make positive outsourcing experience.
Bioinformatics is a fast growing field both at the level of Academia and Industry. We are keen to impart the expertise in genome-informatics through workshops and training programs. Finoseq runs a series of bioinformatics workshops to train researchers in developing their own data analysis methods, and enabling them choose the right tools in their specific research projects. Each workshop includes both lectures and hands-on sessions that helps students or researcher to find their path in their career.
Next-Generation Sequencing could be used for generation of large biological datasets, which can be mined for the identification of novel targets for drug discovery. Using Illumina/Pacbio/HiC/Optical Mapping sequencing allows the rapid generation of a large number of genomes from a single sequencing run. NGS can also be used to support the later stages of drug discovery, such as clinical trials. Next-generation sequencing has the potential to enable further exploration of personalized medicine. We commit to large number of genomics NGS projects for both national as well as international. We have great expertise in Genomics and we constantly endeavour to surpass the expectations of our customers. As a result, we always improvise to enrich their experience of owning a better Genomics services.
Finoseq offers the following genomics and bioinformatics training courses with a focus on improving participants' practical applications, by using the appropriate theoretical knowledge:
- 1. Bioinformatics (Understanding Genomics)
- 2. Custom Data Training Program with your own datasets till publication
- 3. CADD Training Program
- 4. Biomarker Development
- 5. Cancer Bioinformatics
- 6. CRISPR/Cas9 for Genome Editing Training Program
- 7. Phylogenomics
- 8. Advanced R / Perl / Bioperl / Python / Biopython / Java for Biologist
- 9. Next Generation Sequencing (NGS)
WHY CHOOSE US?
We bring solutions to make life easier for our clients.

Benefits to Clients
- 1. Cost-effective High-genome exploring solutions.
- 2. Research-driven cutting edge technology utilization.
- 3. Best in class microarray design service for diverse biological problems.
- 4. Unique database platform integrating genomic data with available database sources to custom panel design.

Strength
- 1. Successfully run Multiple Centers all over India.
- 2. Highest Placement Record in INDIA.
- 3. Well maintained labs with all latest and advanced instruments.
- 4. Highly educated and experienced staff in all Centers
Objectives
- 1. To create an awareness with respect to the basic tools and techniques used in bioinformatics at industrial level.
- 2. To provide complete hands-on-training in the basic tools and techniques.
- 3. To inspire and motivate all life sciences to apply these techniques in their research programmes.
OUR SERVICES
high-quality and extremely effective sequencing-based services to several life science businesses worldwide

The Finoseq, provides high quality and highly efficient sequencing based services to various life science companies across the globe related to core Bioinformatics services and Biotechnology services using cutting edge technology. Finoseq has a great expertise in Genomics and we constantly endeavor to surpass the expectations of our customers. As a result, we always improvise to enrich their experience of owning a better Genomics services. We have a well-coordinated manpower working closely with the group synergizing to strive to foster a team spirit amongst all business units to work as one cohesive umbrella unit.
The Finoseq, provides high quality and highly efficient sequencing based services to various life science companies across the globe related to core Bioinformatics services and Biotechnology services using cutting edge technology. Finoseq has a great expertise in Genomics and we constantly
endeavor to surpass the expectations of our customers. As a result, we always improvise to enrich their experience of owning a better Genomics services. We have a well-coordinated manpower working closely with the group synergizing to strive to foster a team spirit amongst all business units to work as one cohesive umbrella unit.

We focus on innovation in style of Genomics and bringing novelty. All our projects till date have become client satisfactory. Finoseq promises quality assurance, customer focused, reliability and trust from all its Genomics Services. We plan to tie up with world-class research intensive institute, our research and innovation strategy specifically focuses on interdisciplinary approach. In doing so, we are able to address some of the global issues like healthcare, energy crisis and environmental concerns.
We focus on innovation in style of Genomics and bringing novelty. All our projects till date have become client satisfactory. Finoseq promises quality assurance, customer focused, reliability and trust from all its Genomics Services. We plan to tie up with world-class research intensive institute, our research and
innovation strategy specifically focuses on interdisciplinary approach. In doing so, we are able to address some of the global issues like healthcare, energy crisis and environmental concerns.
High calibre and excellent effectiveness
Excellent faculty
Innovative tactics to style
Customer satisfaction
Learn More
50
Completed Projects
100
Happy Customers
10
Expert Employees
4
Awards Won
WORKSHOP / TRAINING
Check out some of our awesome workshop and training.

RNA Transcriptomics (Reference Based)
14 Apr 2022
FUNCTIONAL BIOINFORMATICS

RNA-Transcriptome (Denovo Based)
14 Apr 2022
FUNCTIONAL BIOINFORMATICS

14 Apr 2022
FUNCTIONAL BIOINFORMATICS

Metagenomic Analysis (Shotgun method)
14 Apr 2022
FUNCTIONAL BIOINFORMATICS

Metagenomics (Amplicon-16s) Analysis
14 Apr 2022
FUNCTIONAL BIOINFORMATICS

14 Apr 2022
FUNCTIONAL BIOINFORMATICS

14 Apr 2022
FUNCTIONAL BIOINFORMATICS

CRISPR/Cas9 (Training Will be Update Soon)
14 Apr 2022
FUNCTIONAL BIOINFORMATICS

14 Apr 2022
STRUCTURAL BIOINFORMATICS

Molecular Docking & Molecular Dynamics (Computer Aided Drug Discovery)
14 Apr 2022
STRUCTURAL BIOINFORMATICS
OUR TEAM
Meet Our Team Members
Mrs. A. Sangeetha
Founder & CEO
Dr. S. Vijaya Prabhu Kanna
Scientific Co-Ordinator
Dr. M. Mathavan Muthaiyan
Scientific Co-Ordinator
Mrs. S. Poornam
Scientific Co-Ordinator
Dr. G. Varatharaju
Scientific Co-Ordinator
Dr. Nirmal Kumar
Consultant-Biotechnology
Dr. Beema Shafrin
Technical Advisory Committee Member
Dr. Ponmari Guruvaiah
Technical Advisory Committee Member
Mr. T. Srinivas
Sales & Marketing Support
Ms. S. Deepika
Administrative officer
Mrs. B. Apsara
Wet-Lab Co-ordinator
Mr. S. Mamundi
Sales & Marketing Support
Mr. A. Subash Balaji
Developer
Mr. S. Manoj kanna
Full Stack Developer